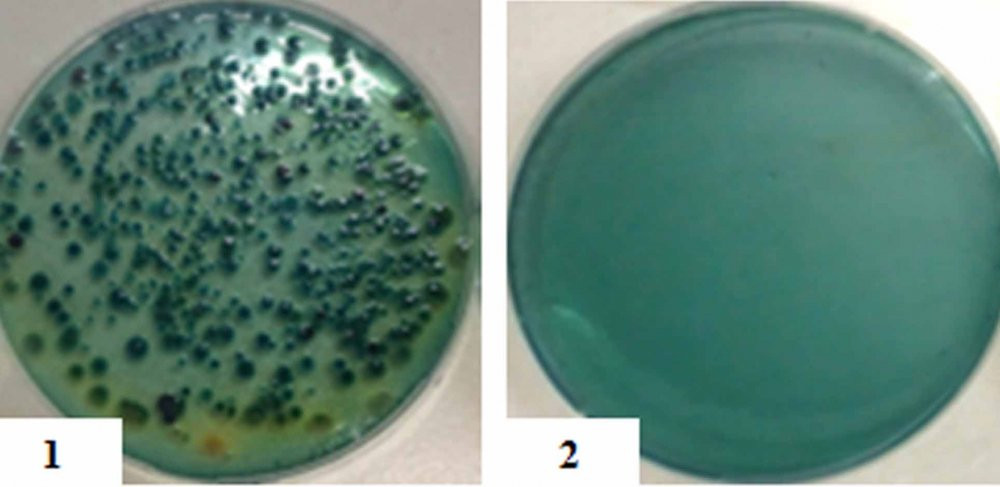
anh2

Đất sét và bã cà phê được trộn đều theo tỉ lệ 2-1 cùng với nước
Cơ chế gốm lọc nước đó là trong quá trình nung, bột cà phê bị cháy sẽ để lại những lỗ trống li ti trong cấu trúc bộ lọc gốm, chúng đủ lớn cho phép nước được lọc qua với tốc độ 1-2 lít/giờ, tùy thuộc vào diện tích đĩa lọc; chúng cũng đủ nhỏ để giữa lại các tạp chất, vi khuẩn.
Bên cạnh đó, một phần cà phê khi cháy sẽ có tác dụng như than hoạt tính nên khử mùi khá tốt, ngoài ra, một lớp tráng bạc làm nhiệm vụ diệt khuẩn để tạo ra sản phẩm cuối cùng là nước sạch.
Theo Thắng và Đạt, trên thế giới đã có bộ lọc được cấu tạo từ đất sét trộn với mùn cưa và nước. Tuy nhiên, nó có một số nhược điểm như chất lượng lỗ xốp không đồng đều, trộn đất sét, mùn cưa khó liên kết... Trong khi đó, bột bã cà phê với kích thước hạt khá mịn, đều, khi trộn vào đất sét sẽ có độ liên kết tốt, độ đồng nhất cao, bã cà phê sau khi nung xong sẽ tạo ra lỗ xốp mịn, đều, chất lượng gốm lọc rất tốt.
Kết quả kiểm nghiệm nước trước khi lọc (ảnh 1) và nước sau khi lọc (ảnh 2)
Khi có nhu cầu sử dụng, người dùng chỉ cần đặt xô đựng nước 20 lít có gắn tấm lọc nước trên một xô đựng nước có thể tích nhỏ hơn (loại xô 15 lít). Sau đó, cho nước vào xô lớn phía trên và từ từ chờ nhận nước sạch ở xô phía dưới.
Qua nhiều kết quả kiểm nghiệm, thiết bị gốm lọc nước cho thấy khả năng ứng dụng vào thực tế rất cao, nhất là ở những vùng thường xuyên bị bão lụt như các tỉnh miền Trung.
Được biết, đề tài của hai em đã đạt giải Nhì cuộc thi Sáng tạo Khoa học Kỹ thuật tỉnh Thừa Thiên Huế năm học 2016-2017, giải Nhất cuộc thi Sáng tạo Thanh thiếu niên, nhi đồng cấp thành phố Huế năm 2017.













